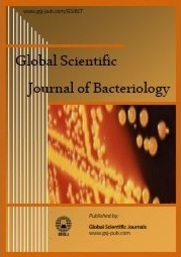

Global Scientific Journal of Bacteriology
Managing Editor
Dr. Colleen Olive
Queensland Institute of Medical Research
PO Royal Brisbane Hospital
Brisbane,
Australia.
West Mediterranean Agricultural Research Institute (BATEM)
Antalya,
Turkey.
Jeju Biodiversity Research Institute (JBRI) and Jeju Hi-Tech Industry Development Institute (HiDI)
Jeju,
Korea.
|